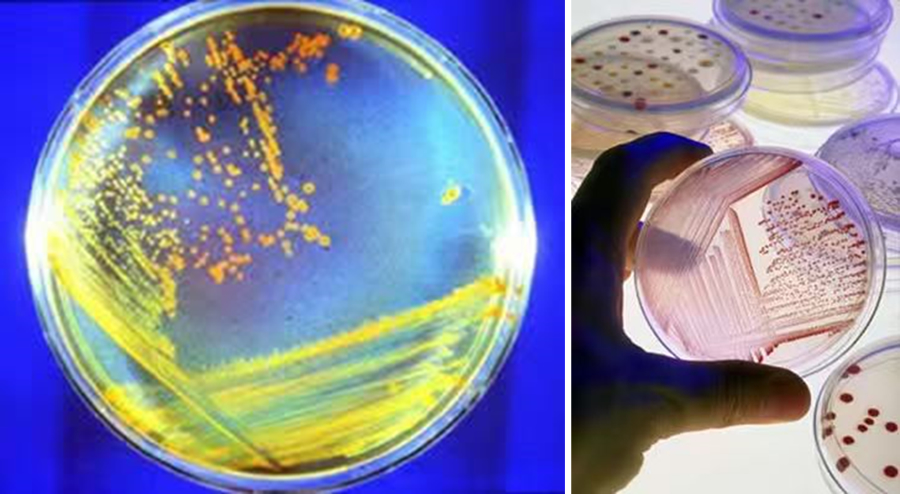

海洋生物种质中心
海洋生物种质中心(CCMBA)包含海洋细菌种质中心(CCMB)和海洋藻类种质中心(CCMA),实现海洋微型藻类和细菌的分离、保藏、分类分析,同时为相关微型生物的筛选、保藏和基础分析提供系列环境、设备、技术。中心运行至今已分离和保藏藻类约1300株、细菌超3300株,为实验室成员提供相关科研和应用支撑服务,同时也为国内外合作者、业内同行提供种质资源服务。
检测项目/服务:海洋生物种质中心提供细菌和藻类素材,细菌和藻类分离、纯化,水体藻类多样性分析等服务和技术支持。
实验室:周隆泉楼A1-317、A1-101
技术人员:高越 gaoyue@xmu.edu.cn ,马维 maw@xmu.edu.cn

|